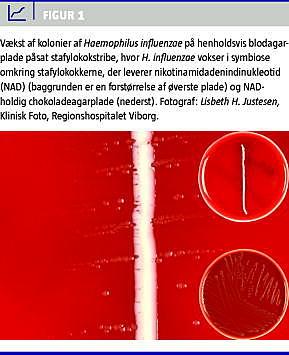

En 31 årig gravida 3, para 2 i gestationsuge 20 + 2 blev indlagt med feber, influenzalignede symptomer og afkortet cervix uteri. I dyrkning af blod og podning fra cervix uteri var der vækst af nonkapsulær Haemophilus influenzae, og der blev opstartet cefuroxim 1,5 g × 3 intravenøst. Senere samme dag aborterede patienten spontant et dødfødt foster. Vi diskuterer sygehistorien, der illustrerer betydningen af opmærksomhed på årsager til febrilia hos gravide.
Septisk abort forårsaget af Haemophilus influenzae af nonkapsulær type er beskrevet kasuistisk siden 1970'erne [1]. I 1991 er bærerhyppigheden af H. influenzae i vagina hos 544 gravide ved terminen opgjort til 0,18% [2]. Hos 3% er infektion årsag til gentagen abort i andet trimester [3]. Der findes ingen opgørelser over hyppigheden af septisk abort forårsaget af H. influenzae .
Ved graviditet er der risiko for ascenderende infektion fra genitalkanalen til amnionhulen samt transplacentær smitte, der kan medføre amnionitis, for tidlig vandafgang, septisk abort og udvikling af neonatal sepsis [4, 5].
Sygehistorie
En 31 årig gravida 3, para 2 i uge 20 + 2 blev set til rutineundersøgelse i ambulatoriet. Patientens første graviditet var ukompliceret. Anden graviditet var kompliceret med placenta prævia og præterm fødsel af en dreng i uge 24, der døde efter få timer.
Patienten havde trykken ned over symfysen, influenzalignende symptomer, rektaltemperatur på 37,7 °C og svag frisk blødning vaginalt. Ved ultralydundersøgelse sås et levende foster med størrelse svarende til gestationsalderen og normal mængde fostervand. Cervix uteri var afkortet til 16 mm mod 33 mm to uger tidligere. Der blev podet fra cervix uteri. Urinstiks var blank.
P-leukocytter var 10 × 109 /l (ref. 3-10) og C-reaktivt protein (CRP) var 108 mg/l (ref. 0-9). Blodtrykket var 110/80 og pulsen 112. Symptomerne blev tolket som influenza, og patienten blev indlagt til sengeleje med toilettilladelse på grund af afkortet cervix. Om aftenen blev der taget bloddyrkning, da temperaturen steg til 39,1 °C.
Dagen efter var patienten afebril, influenzasymptomerne var aftaget og trykken over symfysen var forsvundet. CRP var steget til 160 mg/l. P-leukocytterne var uændret 10 × 109 /l.
Tredje dag blev cervix scannet til 34 mm. Patienten var afebril, men havde et blodtryk på 85/50 og en puls på 100-110. CRP var uændret 160 mg/l, og p-leukocytter var 9 × 109 /l. Klinisk mikrobiologisk afdeling ringede om vækst i bloddyrkningen af små gramnegative stave samt vækst af H. influenzae i podningen fra cervix uteri. Der blev startet behandling med cefuroxim 1,5 g × 3 intravenøst.
Samme dag fik patienten kontraktioner. Der var siven af fostervand og en fosterarm i vagina. Temperaturen steg til 38,8 °C. Fire timer senere fødte hun et dødfødt pigefoster. Der blev suppleret med peroral metronidazol 1 g × 2. Patienten var afebril efter to døgn. Der var nonkapsulær H. influenzae biotype 1 i blod, cervix uteri og overfladepodninger fra fosteret. Stammen var ampicillin- og cefuroximresistent, men følsom for bl.a. ceftriaxon og trimethoprim. Patienten blev udskrevet fire dage post partum med trimethoprim 200 mg × 2 i tolv dage.
Diskussion
Chorioamnionitis giver ikke altid bakteriæmi, og moderen kan være relativt upåvirket ved infektion med H. influenzae [1, 5]. Det kan diskuteres, om vor patient kunne have været behandlet med antibiotika tidligere på mistanke om chorioamnionitis. Det havde muligvis haft betydning for udfaldet, men forholdene var i det aktuelle tilfælde kompliceret af, at H. influenzae -isolatet var resistent overfor såvel ampicillin som cefuroxim, som ofte anvendes i den initiale behandling. En opgørelse på baggrund af udtræk fra Klinisk Mikrobiologisk Afdelings datasystem over tre år af 1.478 isolater viser, at 18% af H. influenzae stammer er rapporteret ampicillinresistente, og i løbet af 2007 er ca. 2% H. influenzae fundet resistente over for cefuroxim. Ved dyrkning af cervixpodninger er det vigtigt at være opmærksom på, at detektion af H. influenzae kræver nikotinamidadenindinukleotid (NAD)-holdigt vækstmedium som f.eks. chokoladeagar og/eller stafylokokstriber med NAD på 5% blodagar (Figur 1 ) [2], hvilket ikke anvendes rutinemæssigt alle steder. H. influenzae er derfor muligvis en overset patogen bakterie i denne sammenhæng.
Det er vigtigt ikke at undervurdere febrilia og andre infektionstegn i forbindelse med graviditet, især hvis patienten har andre symptomer, der er relaterede til abdomen og/eller genitalier. Vi mener, at cervixpodninger fra gravide også bør undersøges for H. influenzae , da bakterien kan forårsage sen abort.
Katrine Fuglsang, Kvindeafdelingen, Regionshospitalet Viborg, DK-8800 Viborg. E-mail: katfugl@hotmail.com
Antaget: 28. november 2008
Interessekonflikter: Ingen
Taksigelse: Overlæge Jørgen Prag takkes for revision af manuskriptet.
<ol class="Litt-list">
<li>Berczy J, Fernlund K, Kamme C. Haemophilus influenzae in septic abortion. Lancet 1973;1:1197.</li>
<li>Schønheyder H, Ebbesen F, Grunnet N et al. Non-capsulated Haemophilus influenzae in the genital flora of pregnant and post-puerperal women. Scand J Infect Dis 1991;23:183-7.</li>
<li>Drakeley AJ, Quenby S, Farquharson RG. Mid-trimester loss - appraisal of screening protocol. Hum Reprod 1998;13:1975-80.</li>
<li>Cherpes TL, Kusne S, Hillier SL. Haemophilus influenzae septic abortion. Infect Dis Obstet Gynecol 2002;10:161-4.</li>
<li>Rusin P, Adam R, Petersen E et al. Haemophilus influenzae: An important cause of maternal and neonatal infections Obstet Gynecol 1991;77:92-6.</li>
</ol>